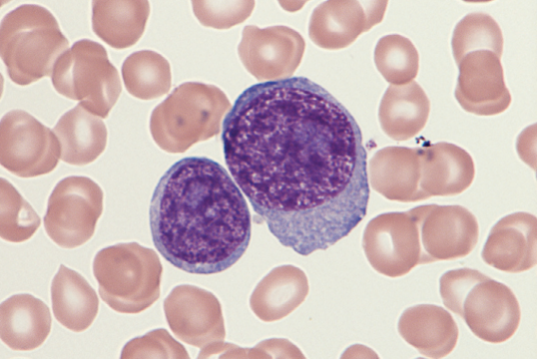
DLBCL

ASCPi-HEMATOLOGY
- Description
- Curriculum
- Reviews
-
1HD TUTORIAL - HEMATOPOIESIS
-
2ERYTHROPOIESIS AND ERYTHROKINETICS
-
3EMP DIVERSION PATHWAYS
-
4HEME BIOSYNTHESIS PATHWAY
Heme biosynthesis occurs in the mitochondria and cytoplasm of bone marrow erythroid precursors
-
5LEUKOPOIESIS AND LEUKOKINETICS
-
6HD TUTORIAL - MEGAKARYOCYTOPOIESIS
Platelets arise from megakaryocytes, the largest cells in the BM (30-50 μm) with a multilobulated nucleus and abundant granular cytoplasm. They possess multiple chromosome copies (polyploid).
Responding to the thrombopoietin (TPO), megakaryocyte progenitors arise from common myeloid progenitors (CFU-GEMM).
-
7MEGAKARYOPOIESIS AND THROMBOPOIESIS
-
8HD TUTORIAL - IRON RESTRICTIVE ANEMIAS
-
9IRON RESTRICTIVE ANEMIAS
-
10HD TUTORIAL - MEGALOBLASTIC AND APLASTIC ANEMIA
-
11MEGALOBLASTIC AND NON-MEGALOBLASTIC ANEMIA
The root cause of megaloblastic anemia is impaired DNA synthesis. When either folate or vitamin B12 is deficient, thymidine nucleotide production for DNA synthesis is impaired. Megaloblastic anemia is one example of a macrocytic anemia.
-
12ANEMIAS OF BONE MARROW FAILURE
-
13HD TUTORIAL - HEMOGLOBINOPATHIES
-
14HEMOGLOBINOPATHIES
-
15THALASSEMIAS
-
16HD TUTORIAL - INTRINSIC HEMOLYTIC ANEMIA
-
17INTRINSIC HEMOLYTIC ANEMIAS
Intrinsic hemolytic anemias comprise a large group of disorders in which defects in the red blood cells (RBCs) result in premature hemolysis and anemia. Intrinsic disorders can be divided into abnormalities of the RBC membrane, metabolic enzymes, or hemoglobin. Most of these defects are hereditary.
-
18HD TUTORIAL - EXTRINSIC HEMOLYTIC ANEMIAS
-
19EXTRINSIC NON-IMMUNE HEMOLYTIC ANEMIAS
-
20EXTRINSIC IMMUNE HEMOLYTIC ANEMIAS
-
21HD TUTORIAL - NON MALIGNANT LEUKOCYTE DISORDERS
-
22NON-MALIGNANT LEUKOCYTE DISORDERS
-
23HD TUTORIAL - ACUTE LEUKEMIA
-
24ACUTE LEUKEMIAS
-
25HD TUTORIAL - MPN
-
26MYELOPROLIFERATIVE NEOPLASMS
-
27HD TUTORIAL - MATURE LYMPHOID NEOPLASMS
-
28HD TUTORIAL PLASMA CELL NEOPLASMS
-
29MATURE LYMPHOID NEOPLASMS
-
30HD TUTORIAL - MDS
-
31MYELODYSPLASTIC SYNDROME AND CYTOCHEMICAL STAINS




